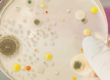
Erneuerung unserer Hygienezertifizierung

Für die professionelle Luftbefeuchtung der Raumluft stehen verschiedene Befeuchtungsverfahren zur Auswahl. Jede der Möglichkeiten birgt ihre Eigenheiten, die den Begebenheiten und Anforderungen vor Ort angepasst werden müssen, um ein fachgerechtes und zielorientiertes Ergebnis zu erreichen. Hier erfahren Sie, welche gängigen Verfahren der Luftbefeuchtung es gibt und zu welchen Kriterien jene passen.
Diverse Befeuchtungsverfahren für optimales Raumklima
Befeuchtungsverfahren übernehmen einen wichtigen Part bei der Erzeugung eines optimalen Raumklimas. Sie befeuchten die Luft punktuell oder raumflächig und regeln die gewünschten Werte der relativen Luftfeuchte.
Zu den bewährten Befeuchtungsverfahren zählen:
- Hochdruckbefeuchter: für sehr große Hallen bis zu Zonenbefeuchtung geeignet
- Ultraschallvernebler: kompakte Geräte für punktuelle Befeuchtung und kleinere Räume
- Druckluftzerstäuber: für geringe Befeuchtungsleistungen bis 10 l/h
- Mobile Luftbefeuchtungsanlagen: für den gezielten Einsatz in bestimmten Bereichen sowie für große Räume ohne Installation
Hochdruckbefeuchter können mittels Direktbefeuchtung im Raum und der Halle oder in einem bestehenden Lüftungsanlagen betrieben werden. Sie erzielen exakte Feuchtewerte und arbeiten sehr hygienisch. Sind sie in einem Lüftungskanal installiert, haben sie den Vorteil, dass in einem Bürokomplex mit verschiedenen kleineren Räumen nicht jeweils eine Befeuchtungsanlage installiert werden muss.
Ultraschallvernebler erzeugen ultrafeinen Wassernebel, der sekundenschnell verdunstet. Die Geräte sind leise, wartungsarm und finden häufig in Messräumen, Laboren oder Lagern mit sensiblen Waren ihren Einsatz.
Mit Druckluftzerstäubern lassen sich kleinste Wassertröpfchen im Bereich von 2 bis 20 µm erzeugen. Sie werden durch den erzeugten Luftdruck zerstäubt und in die Umgebungsluft abgegeben. Da hierfür relativ viel Druckluft benötigt wird, ist dieses Befeuchtungsverfahren nur für geringe Leistungen zu empfehlen.
Der herausragende Vorteil mobiler Luftbefeuchtungsanlagen besteht darin, dass sie flexibel überall dort eingesetzt werden können, wo sie gerade benötigt werden. Zudem sind sie in wenigen Minuten betriebsbereit und erfordern keine Installation, sondern lediglich einen Wasserhahn und eine Steckdose. Gleichwohl eignet sich dieses Befeuchtungsverfahren für den Einsatz als Verdunstungskühler, wodurch beispielsweise das Raumklima in Fertigungsbereichen und Hallen Sommer profitiert.
Fazit zu den Methoden der Luftbefeuchtung
Luftbefeuchtung ist überall dort notwendig, wo ausgewogene Luftfeuchte der Umgebungsluft erforderlich ist. Dies ist insbesondere in Arbeitsräumen und bei Produktionsprozessen der Fall. Dort sorgt geregelte Luftfeuchtigkeit für optimale Bedingungen, welche die Produktivität und den Arbeitsschutz unterstützen.
So unterschiedlich sich die diversen Befeuchtungsverfahren darstellen, sind es auch die Branchen und Bereiche, die mit einem Luftbefeuchter ausgestattet werden sollen. Oftmals gibt der Einsatzort die Art der Befeuchtungsanlage vor. Hierbei spielen bauliche Begebenheiten, Raumgrößen und Anforderungen an den Luftfeuchtigkeitswert eine bedeutende Rolle. Dies sollte gemeinsam mit Fachleuten berücksichtigt werden, damit ein passendes System der Luftbefeuchtung ausgesucht und installiert werden kann.
Nehmen Sie gerne die Beratung unserer Experten von AFT in Anspruch, die Ihnen ein adäquates Befeuchtungsverfahren für Ihre individuellen Räumlichkeiten ausarbeiten!